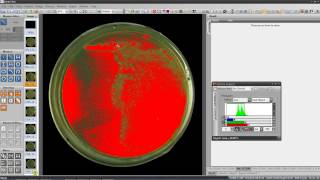

Area Fraction Measurement video
Online izle ve mp4 mp3 formatlarinda yukle

Videonun muddeti: 2:07
Area Fraction Measurement videosu mp4 ve mp3 yuklemek ucun hazirdir
Diqqet! Siz Mp4 yukle ve ya Mp3 yukle duymesine basdiqdan sonra eger sistem sizi reklam sehifesine atarsa o zaman derhal geri qayidib emeliyyati tekrar edin ve faylin yuklemek ucun hazir olmasini gozleyin
Videodan Mp4 Yukle
Videodan Mp3 Yukle-1
Videodan Mp3 Yukle-2
Oxshar Axtarishlar
 Area Fraction Measurement
Area Fraction Measurement Example finding area with fractional sides
Example finding area with fractional sides How to Find the Area of a Rectangle with Fractional Lengths
How to Find the Area of a Rectangle with Fractional Lengths Multiplying Fractions Using Area Models | Math with Mr. J
Multiplying Fractions Using Area Models | Math with Mr. J Math Antics - Area
Math Antics - Area ImageJ - Area Fraction Measurement (Metallography)
ImageJ - Area Fraction Measurement (Metallography) How to caluculate grain size and area (Phase) fraction using ImageJ Sofware in English
How to caluculate grain size and area (Phase) fraction using ImageJ Sofware in English Percentage Change | Rectangle length and breadth change| Rectangle Area % Change Problems | Part 6
Percentage Change | Rectangle length and breadth change| Rectangle Area % Change Problems | Part 6 Intuition for area with fractional side lengths
Intuition for area with fractional side lengths
Video Mp4 Mp3Azwap.Biz
Azwap.Biz 2021-2023

Area Fraction Measurement
Area Fraction Measurement Example finding area with fractional sides
Example finding area with fractional sides How to Find the Area of a Rectangle with Fractional Lengths
How to Find the Area of a Rectangle with Fractional Lengths Multiplying Fractions Using Area Models | Math with Mr. J
Multiplying Fractions Using Area Models | Math with Mr. J Math Antics - Area
Math Antics - Area ImageJ - Area Fraction Measurement (Metallography)
ImageJ - Area Fraction Measurement (Metallography) How to caluculate grain size and area (Phase) fraction using ImageJ Sofware in English
How to caluculate grain size and area (Phase) fraction using ImageJ Sofware in English Percentage Change | Rectangle length and breadth change| Rectangle Area % Change Problems | Part 6
Percentage Change | Rectangle length and breadth change| Rectangle Area % Change Problems | Part 6 Intuition for area with fractional side lengths
Intuition for area with fractional side lengths